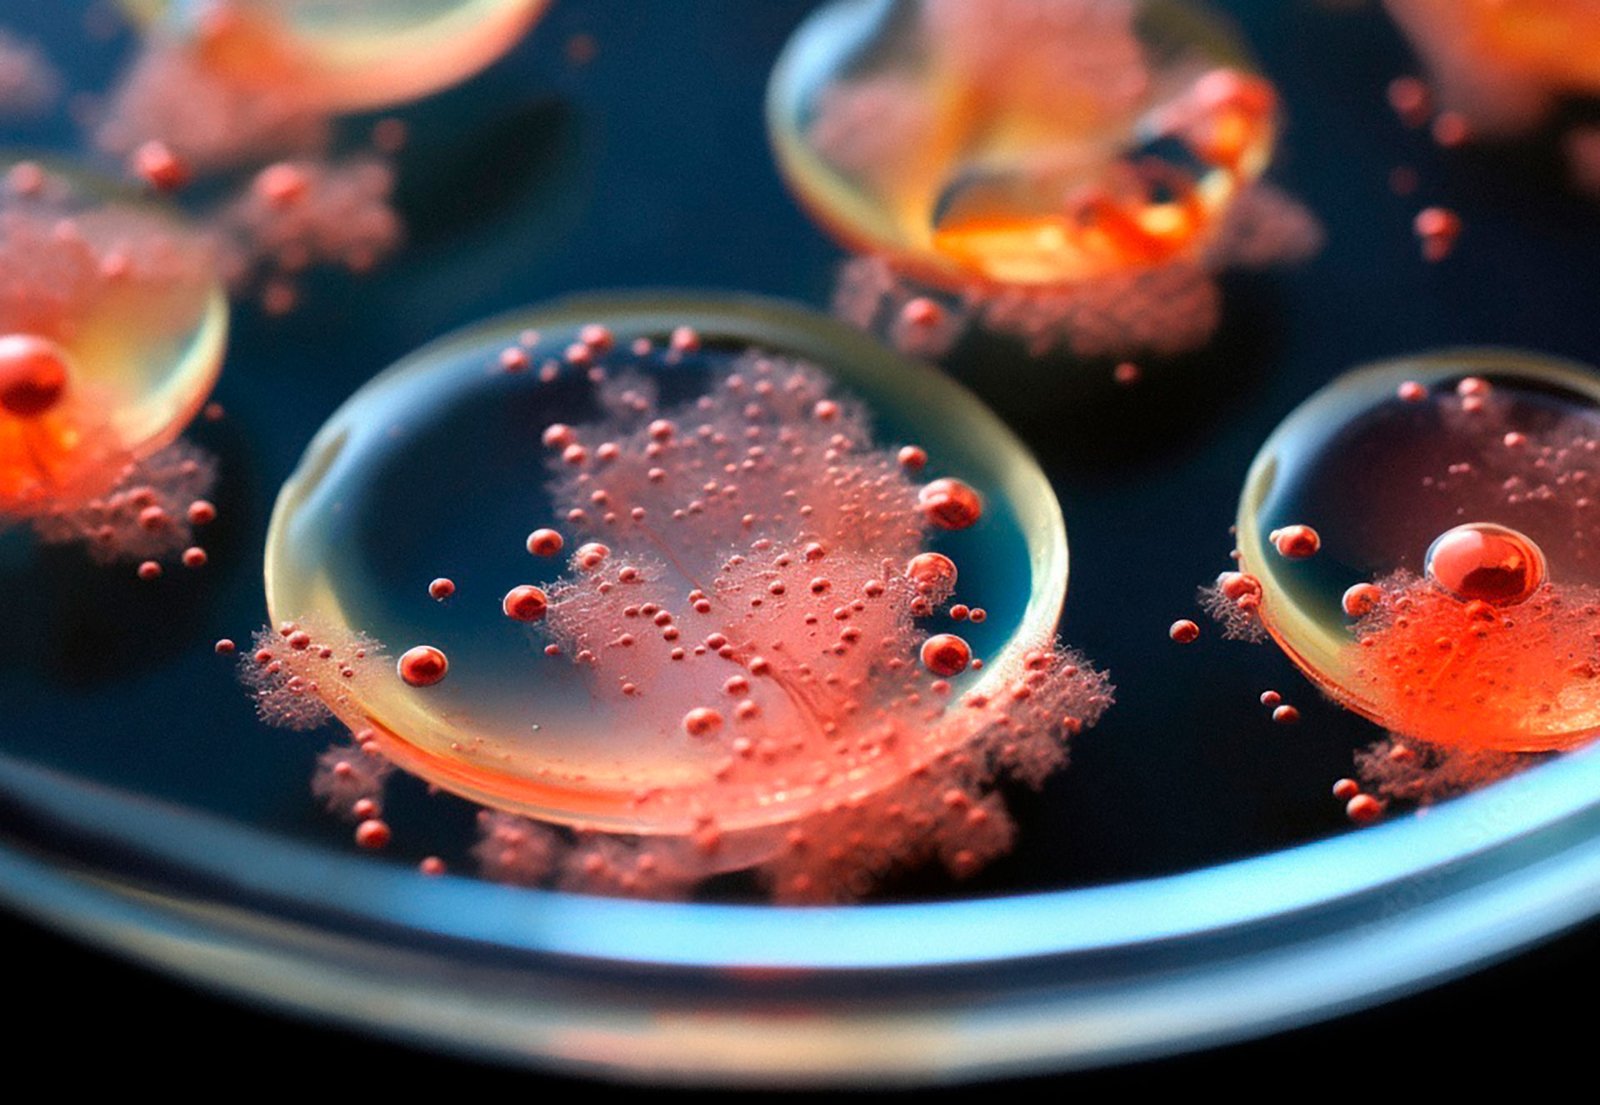

GAPINCE
Through joint efforts, we ensure
effective infection prevention
and a healthy future
Since its inception, the association has been assisting interested parties in deepening their knowledge of infection prevention and control issues in healthcare facilities, and ensuring compliance with existing regulations and international norms.
Our primary goal is to help them strengthen their knowledge and acquire new information, which will ultimately have a positive impact on the quality of medical services and improve treatment outcomes in healthcare facilities.
We strive to promote the development of relevant 21st century skills and competencies by eliminating outdated norms and stereotypes.
Our work aims to reduce the emergence and spread of additional infections during healthcare services by strengthening IPC measures, as well as to reduce the emergence and spread of antibiotic-resistant strains by sharing knowledge about the rational use of antibiotics.
We are participating in the creation and implementation of Georgia's Antimicrobial Resistance Strategy to prevent future threats and achieve sustainable development goals.
We collaborate with government organizations, medical institutions of various profiles and sizes, civil society, and international partners in a joint effort to improve infection prevention and control issues, which are extremely important today all over the world.